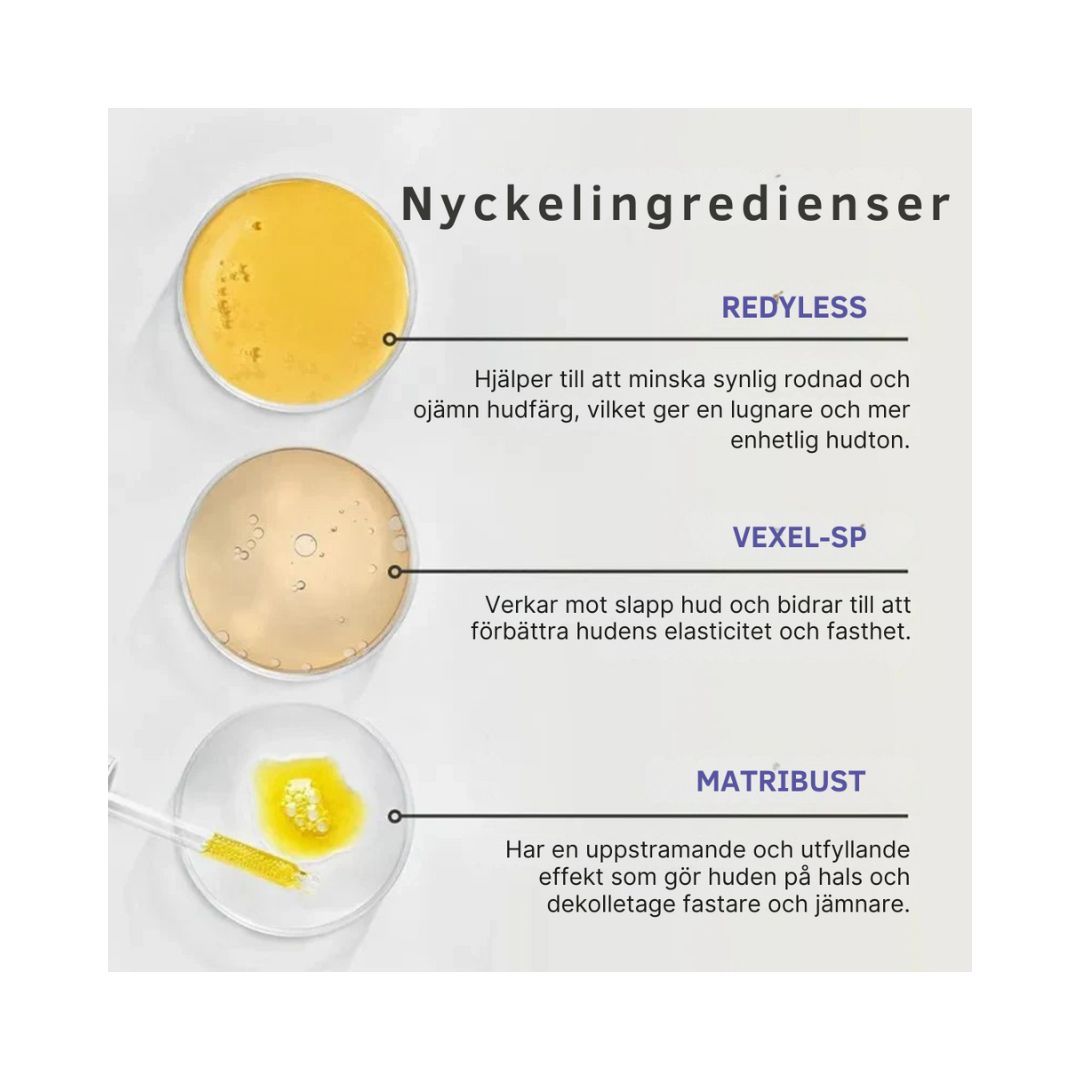

Strammende nakke & Dekolletékrem
Strammende nakke & Dekolletékrem
På lager
Kunne ikke laste ned tilgjengelighet
Du har kanskje allerede lagt merke til det – hvordan huden under haken begynner å føles tynnere, mindre elastisk og vanskeligere å «fjerne». Rynker er mer synlige i visse vinkler. Halsen mister konturen. Det er helt naturlig – men det betyr ikke at du må akseptere det.
Halsen er et av de første områdene som eldes. Huden er tynnere, kollagen brytes ned raskere, og det er færre talgkjertler som beskytter mot tørrhet og tap av elastisitet. Samtidig er halsen noe vi sjelden gir spesielt vare på – før den plutselig blir synlig.
Fast && Løft™ er utviklet spesielt for dette sensitive området – for å bygge opp, løfte og hydrere med presisjon.
Resultater er ofte merkbare innen 3–5 uker: glattere linjer, en fastere følelse og en mer definert nakkekontur.
Med aktive ingredienser som Redyless®, Vexel-SP™ og Matribust™, gir stramt && Lift™ dokumentert effekt på fasthet, hudtekstur og fuktighetsbalanse.
Det er aldri for sent å gi nakken din den pleien den fortjener.







Nakke & Dekolletékrem – målrettet hudpleie for fasthet, fuktighet og glød
Nakke & Decolleté Cream er en nærende og silkemyk formel med Matribust™, hyaluronsyre, koffein og cupuaçusmør – utviklet for å hydrere, styrke og synlig forbedre hudens fasthet i det sensitive området mellom haken og brystet. Fri for parfyme, parabener og uttørkende alkoholer.
Formelen er spesielt tilpasset tynn og moden hud som lett mister elastisitet. Den bidrar til å redusere fine linjer, jevne ut hudtonen og gjenopprette elastisiteten – uten å føles fet eller tung. Perfekt for de som ønsker å gi halsen samme pleie som ansiktet, med en aktiv, men skånsom behandling som passer både morgen og kveld.
Ingredienser
En formel laget for den mest krevende huden
Fast & Lift™ kombinerer fire aktive ingredienser utvalgt for sine dokumenterte egenskaper for å forbedre hudens fasthet og tekstur – uten å irritere eller overstimulere:
• 4 % cupuaçu-smør
Et plantebasert alternativ til silikon – men naturlig. Cupuaçu utvinnes fra frukten fra Amazonas regnskog og binder fuktighet opptil 240 % mer effektivt enn sheasmør. Resultatet? En fyldig, hydrert hudbarriere som ser glattere ut dag for dag.
• 2 % Matribut
Et bioteknologisk aktivt stoff som i studier har vist seg å øke hudens tetthet og elastisitet i byste- og halsområdet. Det fungerer der tradisjonelle kremer mislykkes – der huden er tynn og strukturen trenger støtte nedenfra.
• Koffein
En kraftig mikrodrenerende ingrediens som reduserer hevelse, forbedrer mikrosirkulasjonen og gir huden en fastere og mer tonet følelse. Ideell for å bekjempe «trøtt» hud eller en lett dobbelthake.
• Hydrolysert hyaluronsyre
Ikke bare fuktighet – men fuktighet som virkelig trenger inn. Ved å bruke hydrolysert (lavmolekylær) hyaluronsyre fylles fine linjer ut innenfra, og huden blir merkbart glattere etter den første uken.
Innhold som kan skjules
Ingredienser
Vann, Prunus Amygdalus Dulcis-olje, isopropylpalmitat, Simmondsia Chinensis-frøolje, isostearylpolyglyseryl-3-dimetikon, sorbitanseskvioleat, magnesiumaluminiumsilikat, aloe barbadensis-bladekstrakt, rosa rugosa-blomsterolje, fenoksyetanol, CI 77492, CI 77491, CI 77499, CI 77891.

Synlige resultater - uten nåler eller klinikkbesøk
Dette er et produkt for deg som:
• Ser begynnende eller tydelige tegn på tap av fasthet på halsen eller brystet
• Ønsker en behandling som faktisk bygger opp – ikke bare fukter
• Har vurdert estetiske prosedyrer, men ønsker å prøve et dokumentert alternativ først
• Ønsker å gjenvinne en følelse av løft, elastisitet og kontroll
Silkemyk, parfymefri og trygg
Denne stramme & Lift Neck and Décolleté Cream har en lett, men nærende tekstur som raskt trekker inn i huden uten å etterlate klissete rester. Formelen er parfymefri, vegansk og dermatologisk testet for sensitiv hud – egnet for alle hudtyper, selv moden eller solskadet hud.
50 ml – varer i 4–6 uker ved daglig bruk
Produsert i henhold til GMP-standarder
Ikke testet på dyr

Få først, betal senere med Klarna
Hvordan bruke den:
Formelen er utviklet for å forbedre den delikate huden på hals og bryst innen 4–8 uker. For raskere resultater anbefales daglig bruk.
- Rens huden grundig (morgen og/eller kveld)
- Masser en liten mengde oppover fra kragebeinet til kjevelinjen
- La det trekke inn i 1–2 minutter
- Brukt
Tips: Kombiner med mild peeling én gang i uken for maksimal effekt.

Basert på over 3000+ anmeldelser!
«Huden under haken min føltes løs etter vekttapet – nå ser alt mye fastere ut.»
– Linda F.
«Jeg har prøvd både klinikkbehandlinger og dyre serumer, men denne kremen er den første som faktisk gjør en forskjell. Halsen min ser ut som den gjorde for åtte år siden.»
– Therese N.
«Den første halskremen som faktisk gjør noe. Dobbelthaken er ikke like tydelig lenger.»
– Sarah E.

For de som vil se en virkelig endring.
Huden på halsen og brystet forandrer seg med årene – og det er helt naturlig.
Men det betyr ikke at du ikke kan gjøre noe med det.
Denne kremen er utviklet for å gi synlige resultater, selv på moden hud.
Og så langt har ikke en eneste kunde bedt om refusjon.
Ikke en eneste negativ anmeldelse.
Hvis du mot formodning ikke ser noen effekt, vil du selvfølgelig få full refusjon innen 60 dager.
Fordi livet er for kort til å ikke være komfortabel i sin egen hud.
Spørsmål? Vi har svarene!
Hvordan bruker jeg kremen til best resultat?
Påfør morgen og kveld på renset hud. Masser kremen forsiktig inn med oppadgående bevegelser fra kragebeinene til kjevelinjen.
Når kan jeg forvente å se resultater?
Mange brukere rapporterer synlige forbedringer innen 4–8 uker med daglig bruk. For best resultat anbefaler vi å bruke to bokser i løpet av denne perioden.
Er produktet trygt for sensitiv hud?
Ja, kremen er parfymefri, vegansk og dermatologisk testet for sensitiv hud.
Hva er de aktive ingrediensene?
Kremen inneholder blant annet:
- Cupuaçu-smør – for dyp hydrering
- Koffein – stimulerer sirkulasjonen og reduserer hevelse
- Hydrolysert hyaluronsyre – forbedrer hudens fuktighetsbalanse og fasthet
- Matribust™ – øker hudens elastisitet og løfter slapp hud
Er produktet fritt for skadelige stoffer?
Ja, den er fri for parabener, sulfater, ftalater, syntetiske dufter og fargestoffer.
Hva om jeg ikke ser noen resultater?
60-dagers kundetilfredshetsgaranti
Vi er så sikre på produktet vårt at vi tilbyr en 60-dagers fornøydhetsgaranti. Hvis du ikke er fornøyd med resultatene, får du full refusjon – uten problemer.
📸 Tupp: For best resultat anbefaler vi at du tar før- og etterbilder. Disse bildene kan også være nødvendige som grunnlag hvis du vil bruke garantien, slik at vi enkelt kan se fremgangen din.
Testet i Nederland – med imponerende resultater
Under en uavhengig brukertest i Nederland, 40 kvinner mellom 38 og 74 år.
De brukte kremen daglig i åtte uker og registrerte opplevelsene sine hver uke.
Resultatet?
- 95 % opplevde en tydelig reduksjon i halsutringningen
- 93 % la merke til at fine linjer ble lysere og glattere
- 92 % opplevde en mer definert og fastere nakkekontur
- 94 % opplevde at huden på halsen ble lysere og klarere
➤ Resultatene er basert på deltakernes personlige erfaringer

Testet i Nederland - med imponerende resultater
Under en uavhengig brukertest i Nederland, 40 kvinner mellom 38 og 74 år.
De brukte kremen daglig i åtte uker og registrerte opplevelsene sine hver uke.
Resultatet?
- 95 % opplevde en tydelig reduksjon i halsutringningen
- 93 % la merke til at fine linjer ble lysere og glattere
- 92 % opplevde en mer definert og fastere nakkekontur
- 94 % opplevde at huden på halsen ble lysere og klarere
➤ Resultatene er basert på deltakernes personlige erfaringer
Jag har torr och tunn hud på halsen, men efter att ha använt den här krämen har den blivit märkbart mjukare och mer elastisk. Jag är väldigt glad att jag äntligen hittat en produkt som verkligen fungerar.
Efter bara några veckor märkte jag en tydlig skillnad på min hals och dekolletage. Huden känns fastare och mycket mjukare. 🤩🤩
Jag har torr och tunn hud på halsen, men efter att ha använt den här krämen har den blivit märkbart mjukare och mer elastisk. Jag är väldigt glad att jag äntligen hittat en produkt som verkligen fungerar.
Jag har torr och tunn hud på halsen, men efter att ha använt den här krämen har den blivit märkbart mjukare och mer elastisk. Jag är väldigt glad att jag äntligen hittat en produkt som verkligen fungerar.
Efter bara några veckor märkte jag en tydlig skillnad på min hals och dekolletage. Huden känns fastare och mycket mjukare. 🤩🤩
Efter bara några veckor märkte jag en tydlig skillnad på min hals och dekolletage. Huden känns fastare och mycket mjukare. 🤩🤩













